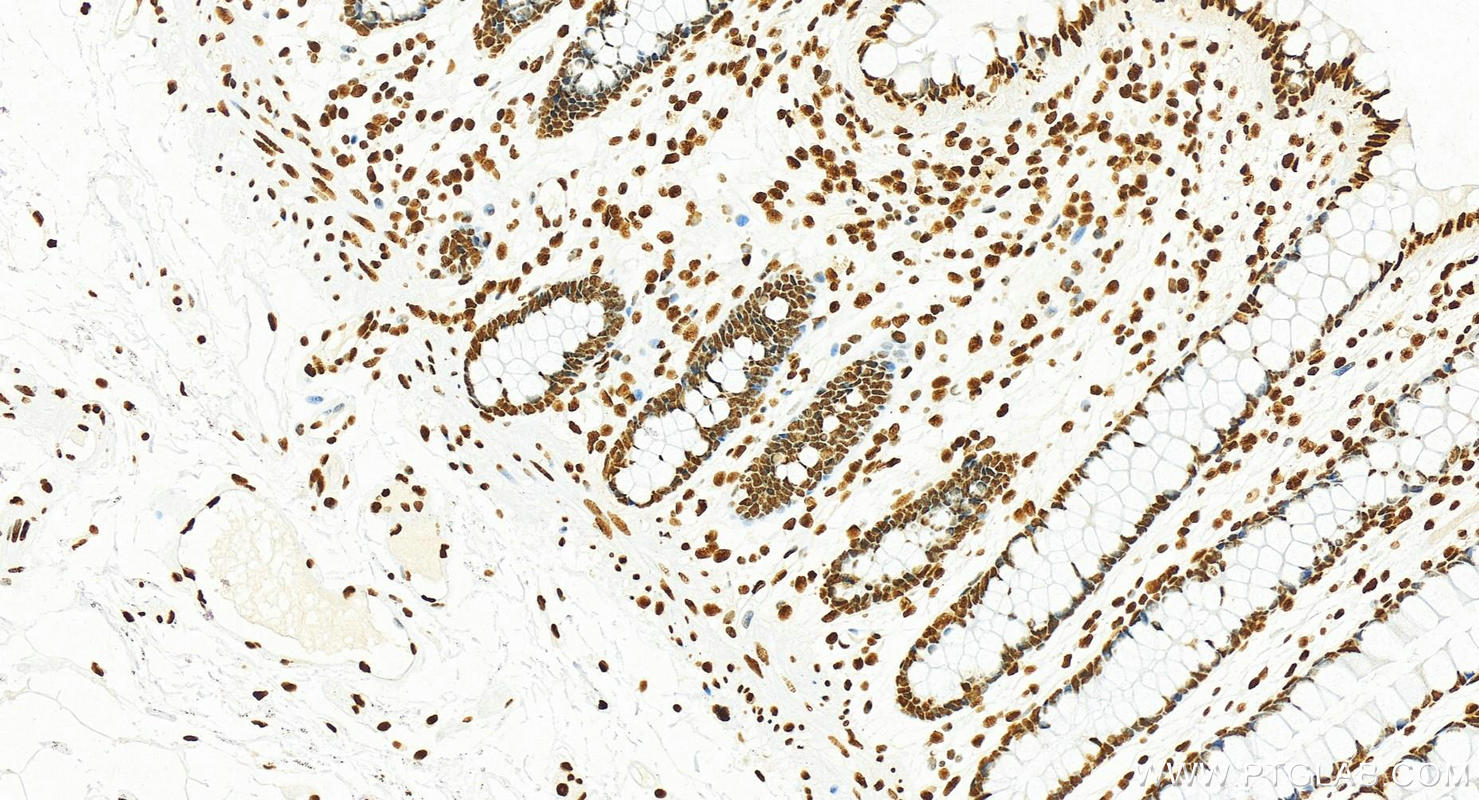
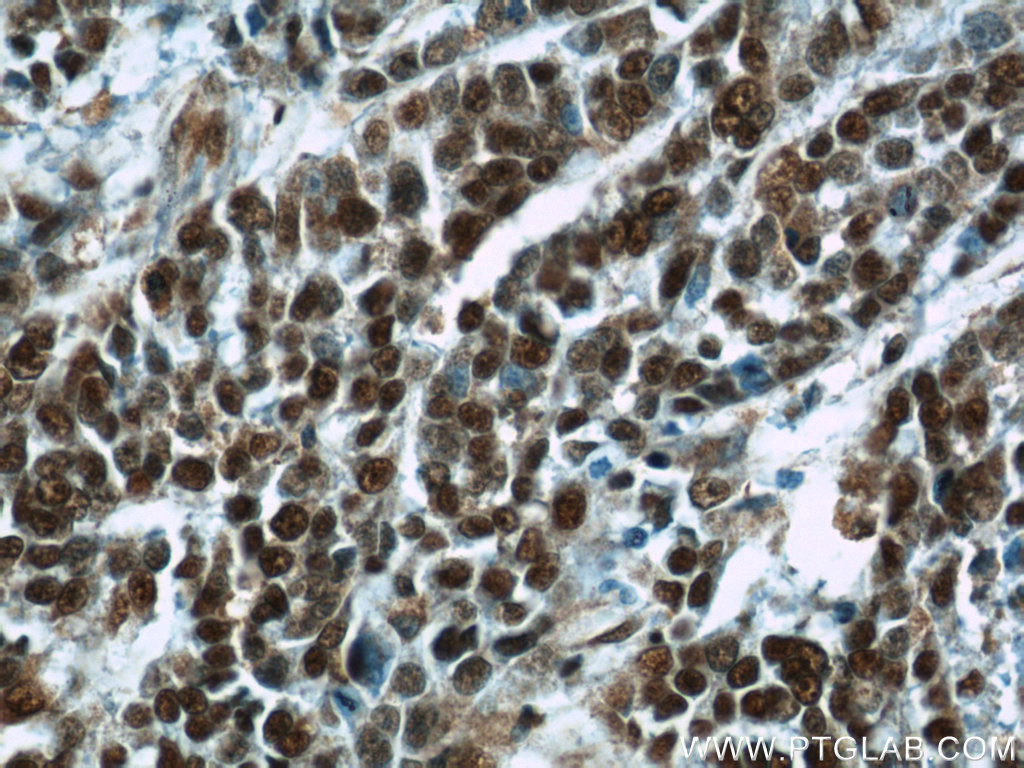

验证数据展示
经过测试的应用
| Positive WB detected in | COLO 320 cells, Jurkat cells, multi-cells, K-562 cells, HeLa cells, HEK-293 cells |
| Positive IP detected in | Jurkat cells |
| Positive IHC detected in | human colon cancer tissue, human breast cancer tissue, human normal colon Note: suggested antigen retrieval with TE buffer pH 9.0; (*) Alternatively, antigen retrieval may be performed with citrate buffer pH 6.0 |
| Positive IF/ICC detected in | HeLa cells |
推荐稀释比
| 应用 | 推荐稀释比 |
|---|---|
| Western Blot (WB) | WB : 1:20000-1:100000 |
| Immunoprecipitation (IP) | IP : 0.5-4.0 ug for 1.0-3.0 mg of total protein lysate |
| Immunohistochemistry (IHC) | IHC : 1:250-1:1000 |
| Immunofluorescence (IF)/ICC | IF/ICC : 1:400-1:1600 |
| It is recommended that this reagent should be titrated in each testing system to obtain optimal results. | |
| Sample-dependent, Check data in validation data gallery. | |
产品信息
10306-1-AP targets B23/NPM1 in WB, IHC, IF/ICC, IP, CoIP, chIP, ELISA applications and shows reactivity with human, rat samples.
| 经测试应用 | WB, IHC, IF/ICC, IP, ELISA Application Description |
| 文献引用应用 | WB, IHC, IF, IP, CoIP, chIP |
| 经测试反应性 | human, rat |
| 文献引用反应性 | human, mouse, rat, pig |
| 免疫原 |
CatNo: Ag0286 Product name: Recombinant human B23 protein Source: e coli.-derived, PGEX-4T Tag: GST Domain: 1-293 aa of BC002398 Sequence: MEDSMDMDMSPLRPQNYLFGCELKADKDYHFKVDNDENEHQLSLRTVSLGAGAKDELHIVEAEAMNYEGSPIKVTLATLKMSVQPTVSLGGFEITPPVVLRLKCGSGPVHISGQHLVAVEEDAESEDEEEEDVKLLSISGKRSAPGGGSKVPQKKVKLAADEDDDDDDEEDDDEDDDDDDFDDEEAEEKAPVKKSIRDTPAKNAQKSNQNGKDSKPSSTPRSKGQESFKKQEKTPKTPKGPSSVEDIKAKMQASIEKGGSLPKVEAKFINYVKNCFRMTDQEAIQDLWQWRKS 种属同源性预测 |
| 宿主/亚型 | Rabbit / IgG |
| 抗体类别 | Polyclonal |
| 产品类型 | Antibody |
| 全称 | nucleophosmin (nucleolar phosphoprotein B23, numatrin) |
| 别名 | B23, NPM1, NPM, Nucleophosmin, Numatrin |
| 计算分子量 | 33 kDa |
| 观测分子量 | 35-40 kDa |
| GenBank蛋白编号 | BC002398 |
| 基因名称 | NPM1 |
| Gene ID (NCBI) | 4869 |
| RRID | AB_2155163 |
| 偶联类型 | Unconjugated |
| 形式 | Liquid |
| 纯化方式 | Antigen affinity purification |
| UNIPROT ID | P06748 |
| 储存缓冲液 | PBS with 0.02% sodium azide and 50% glycerol, pH 7.3. |
| 储存条件 | Store at -20°C. Stable for one year after shipment. Aliquoting is unnecessary for -20oC storage. |
背景介绍
Nucleophosmin (NPM1,B23) is a putative ribosome assembly factor with a high affinity for peptides containing nuclear localization signals (NLSs). The transport of proteins across the nuclear envelope is a selective, multistep process involving several cytoplasmic factors. Proteins must be recognized as import substrates, dock at the nuclear pore complex and translocate across the nuclear envelope in an ATP-dependent fashion. Several cytosolic and nuclear proteins that are central to this process have been identified. The 38 kDa nuclear protein nucleophosmin is involved in ribosomal assembly and rRNA transport. It is an abundant protein that is highly phosphorylated by Cdc2 kinase during mitosis. NPM1 can interact with multiple proteins to form complexes, so the detected molecular weight may sometimes increase.
实验方案
| Product Specific Protocols | |
|---|---|
| IF protocol for B23/NPM1 antibody 10306-1-AP | Download protocol |
| IHC protocol for B23/NPM1 antibody 10306-1-AP | Download protocol |
| IP protocol for B23/NPM1 antibody 10306-1-AP | Download protocol |
| WB protocol for B23/NPM1 antibody 10306-1-AP | Download protocol |
| Standard Protocols | |
|---|---|
| Click here to view our Standard Protocols |
发表文章
| Species | Application | Title |
|---|---|---|
EMBO Mol Med Excess hydrogen sulfide and polysulfides production underlies a schizophrenia pathophysiology. | ||
Cancer Res LNMICC promotes nodal metastasis of cervical cancer by reprogramming fatty acid metabolism. | ||
Int J Mol Sci TRPV1 Activation Promotes β-arrestin2 Interaction with the Ribosomal Biogenesis Machinery in the Nucleolus:Implications for p53 Regulation and Neurite Outgrowth. | ||
Mol Ther Nucleic Acids RPL32 Promotes Lung Cancer Progression by Facilitating p53 Degradation. | ||